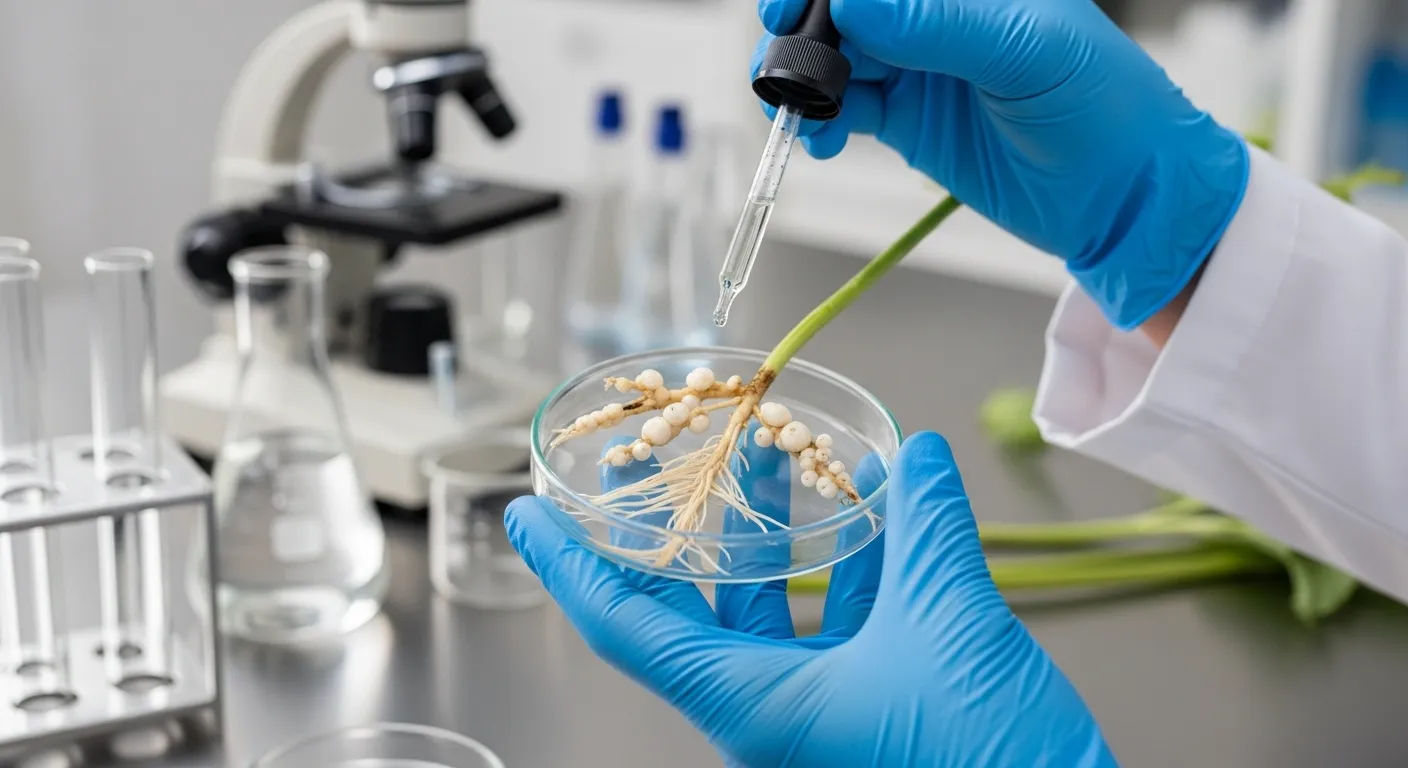
root knot nematode treatment

Root Knot Nematode Treatment Control Methods

- 1.
What Exactly Are Root-Knot Nematodes?
- 2.
Recognizing the Telltale Signs of Infestation
- 3.
Chemical Control Methods for Root-Knot Nematodes
- 4.
Organic and Biological Treatment Options
- 5.
Cultural Practices for Long-Term Management
- 6.
Resistant Plant Varieties and Grafting Techniques
- 7.
Soil Amendments and Natural Repellents
- 8.
Prevention Strategies to Keep Nematodes at Bay
- 9.
Integrated Pest Management for Sustainable Control
- 10.
Putting Your Root Knot Nematode Treatment Plan into Action
Table of Contents
root knot nematode treatment
What Exactly Are Root-Knot Nematodes?
Ever dug up one of your prized tomato plants only to find the roots looking like they've been tied into a bunch of tiny, gnarly knots? Yeah, that's the handiwork of root-knot nematodes—those microscopic little buggers that can turn your garden dreams into a nightmare faster than you can say "what the heck happened to my plants?" These tiny roundworms are basically the ninjas of the pest world: invisible to the naked eye, silent in their attack, and absolutely devastating to your crops. When we talk about root knot nematode treatment, we're dealing with one of the most frustrating challenges any gardener can face. These pests invade plant roots, causing those characteristic swellings or "galls" that disrupt water and nutrient uptake. The result? Stunted growth, yellowing leaves, and plants that just refuse to thrive no matter how much love and fertilizer you throw their way. It's like your plants are slowly suffocating underground while you stand there scratching your head wondering what you did wrong.
Recognizing the Telltale Signs of Infestation
So how do you know if you've got a root knot nematode treatment situation on your hands? Well, sugar, the symptoms above ground can be pretty sneaky. Your plants might look generally unhappy—wilting even when the soil's moist, showing poor growth despite adequate feeding, or producing smaller fruits than usual. But the real smoking gun is underground. When you pull up an affected plant, instead of seeing nice, smooth white roots, you'll find these weird, swollen knots or beads along the root system. It's like someone took your plant's roots and tied them into little bows. The severity can range from a few small galls to roots that are so distorted they barely function at all. And here's the kicker—different plant species show different levels of susceptibility. Tomatoes, peppers, eggplants, and okra are basically nematode buffets, while marigolds and certain resistant varieties can hold their own. Recognizing these signs early is crucial for effective root knot nematode treatment before the infestation spreads throughout your entire garden.
Chemical Control Methods for Root-Knot Nematodes
Alright, let's get down to brass tacks—what pesticide kills root-knot nematodes? The short answer is that there are several chemical options available, but they come with some serious caveats. Traditional nematicides like fenamiphos or ethoprop were once the go-to solutions for root knot nematode treatment, but many have been phased out due to environmental concerns and toxicity issues. These chemicals work by disrupting the nematodes' nervous systems, but they can also harm beneficial soil organisms and potentially leach into groundwater. For home gardeners, products containing abamectin or fluopyram might be available, but they're typically restricted-use pesticides that require special licensing. The reality is that chemical control for root knot nematode treatment is becoming less viable for the average gardener, which is why many experts now recommend integrated approaches that combine multiple strategies rather than relying solely on chemical warfare.
Organic and Biological Treatment Options
Thankfully, Mother Nature has provided us with some pretty clever solutions for root knot nematode treatment that don't involve harsh chemicals. One of the most effective organic approaches is using beneficial nematodes—yes, you read that right! While root-knot nematodes are the bad guys, there are other species of nematodes that actually prey on them. Products containing Steinernema or Heterorhabditis species can be applied to the soil, where they seek out and destroy the root-knot nematodes. It's like sending in the cavalry to fight the invaders! Another powerful weapon in your organic arsenal is neem oil, which has natural nematicidal properties. When applied as a soil drench, neem oil can suppress nematode populations while being safe for beneficial insects and soil microbes. For root knot nematode treatment, these biological controls offer a sustainable approach that works with nature rather than against it.
Cultural Practices for Long-Term Management
Sometimes the best root knot nematode treatment isn't about what you add to your garden, but what you change about how you garden. Crop rotation is absolutely essential—don't plant susceptible crops in the same spot year after year. Instead, rotate with non-host plants like corn, onions, or garlic, which nematodes can't feed on. Soil solarization is another game-changer, especially in warm climates. By covering moist soil with clear plastic during the hottest months, you can literally cook the nematodes (and other pests) to death with temperatures reaching 120°F or higher. Adding organic matter like compost or well-rotted manure also helps by encouraging beneficial microorganisms that compete with or prey on nematodes. When it comes to root knot nematode treatment, these cultural practices form the foundation of a sustainable management strategy that builds soil health while suppressing pest populations.
Resistant Plant Varieties and Grafting Techniques
Here's a secret weapon for root knot nematode treatment that many gardeners overlook: planting resistant varieties. Many seed companies now offer tomato, pepper, and other vegetable varieties with built-in resistance to root-knot nematodes, indicated by an "N" after the variety name. These plants have natural defenses that prevent nematodes from establishing feeding sites, effectively shutting down the infestation before it starts. For serious gardeners, grafting susceptible varieties onto resistant rootstock is another powerful technique. You get the best of both worlds—the flavor and characteristics of your favorite varieties combined with the nematode resistance of hardy rootstock. It might sound fancy, but grafting has become much more accessible to home gardeners in recent years. When dealing with persistent root knot nematode treatment challenges, these genetic solutions can be absolute lifesavers.
Soil Amendments and Natural Repellents
Believe it or not, what you add to your soil can make a world of difference in your root knot nematode treatment strategy. Certain plants, when incorporated into the soil as green manure, actually release compounds that repel or kill nematodes. Marigolds (Tagetes species) are the classic example—planting them as a cover crop and then tilling them under can significantly reduce nematode populations. Mustard greens and other brassicas work similarly, releasing glucosinolates that are toxic to nematodes. Even simple amendments like crushed eggshells or diatomaceous earth can create physical barriers that make it harder for nematodes to move through the soil. For effective root knot nematode treatment, think of your soil as a living ecosystem that you can manipulate to favor your plants over the pests.
Prevention Strategies to Keep Nematodes at Bay
As the old saying goes, an ounce of prevention is worth a pound of cure—and that's especially true when it comes to root knot nematode treatment. Start with clean, nematode-free planting material, and always quarantine new plants before introducing them to your garden. Avoid moving soil from infested areas to clean ones, and clean your tools thoroughly between uses. Maintaining optimal soil pH and fertility also helps plants resist nematode damage—even if nematodes are present, healthy plants can often tolerate low levels of infestation. Regular soil testing can alert you to nematode problems before they become severe, giving you time to implement control measures. The key to successful root knot nematode treatment is creating an environment where nematodes struggle to establish themselves in the first place.
Integrated Pest Management for Sustainable Control
The most effective approach to root knot nematode treatment isn't any single method—it's combining multiple strategies into an integrated pest management (IPM) plan. This means using resistant varieties as your foundation, rotating crops to break the nematode life cycle, incorporating organic amendments to boost soil health, and applying biological controls when needed. IPM recognizes that complete eradication is rarely possible or desirable; instead, the goal is to keep nematode populations below damaging levels while maintaining a healthy, balanced ecosystem. This holistic approach to root knot nematode treatment not only controls pests more effectively but also builds long-term soil fertility and reduces reliance on external inputs. It's gardening wisdom at its finest—working with nature rather than fighting against it.
Putting Your Root Knot Nematode Treatment Plan into Action
Now that you've got the knowledge, it's time to take action on your root knot nematode treatment strategy! Start by assessing your garden's current situation—where are the problem areas, and which crops are most affected? Then develop a multi-year plan that incorporates crop rotation, soil amendments, and resistant varieties. Remember, nematode management is a marathon, not a sprint. For more expert advice on creating thriving gardens, visit the Potaday homepage where we share practical tips for gardeners of all levels. Dive deeper into cultivation techniques in our Growing category, packed with resources to help your plants flourish. And if you're looking for comprehensive solutions to nematode challenges, don't miss our detailed guide on Root Nematode Control: Garden Solutions that covers everything from prevention to advanced treatment methods.
Frequently Asked Questions
What pesticide kills root-knot nematodes?
Several pesticides can kill root-knot nematodes, though availability varies by region and regulations. Abamectin and fluopyram are commonly used nematicides that target these pests by disrupting their nervous systems. However, many traditional chemical options have been restricted due to environmental concerns. For home gardeners seeking root knot nematode treatment, biological controls like beneficial nematodes (Steinernema and Heterorhabditis species) offer effective alternatives without the environmental risks associated with synthetic pesticides. Always check local regulations and consider integrated approaches that combine multiple control methods for sustainable root knot nematode treatment.
How do you chemically control root-knot nematodes?
Chemical control of root-knot nematodes typically involves applying nematicides to the soil before or during planting. Products containing active ingredients like abamectin, fluopyram, or oxamyl can be effective for root knot nematode treatment, though many require professional application due to their toxicity. Soil fumigants like 1,3-dichloropropene were once widely used but have faced increasing restrictions. For chemical root knot nematode treatment to be successful, proper timing and application methods are crucial, as these products must reach nematodes in the root zone. However, chemical control alone is rarely sufficient—combining it with cultural practices and biological controls provides more sustainable long-term management of root-knot nematode populations.
What is nematode treatment?
Nematode treatment refers to any method used to control or eliminate harmful nematodes from soil or plants. For root knot nematode treatment specifically, this includes chemical nematicides, biological controls using beneficial organisms, cultural practices like crop rotation and soil solarization, and planting resistant varieties. Effective nematode treatment requires an integrated approach that addresses the entire life cycle of these pests while maintaining soil health. The goal isn't necessarily complete eradication—which is often impossible—but rather reducing populations to levels where they don't cause significant damage to crops. Successful root knot nematode treatment strategies vary depending on the specific nematode species, crop type, soil conditions, and environmental factors involved.
Can beneficial nematodes kill root-knot nematodes?
Yes, certain species of beneficial nematodes can effectively control root-knot nematodes as part of an integrated root knot nematode treatment strategy. Beneficial nematodes like Steinernema feltiae and Heterorhabditis bacteriophora are predatory species that actively seek out and kill pest nematodes, including root-knot varieties. These beneficial organisms enter the bodies of pest nematodes and release bacteria that kill them within 48 hours. When applied properly to moist soil, beneficial nematodes can significantly reduce root-knot nematode populations without harming plants, earthworms, or other beneficial soil organisms. This biological control method offers an environmentally friendly alternative to chemical pesticides for sustainable root knot nematode treatment.
References
- https://www.apsnet.org/edcenter/disandpath/nematode/pdlessons/Pages/RootKnot.aspx
- https://extension.uga.edu/publications/detail.html?number=B1138
- https://www.ncbi.nlm.nih.gov/pmc/articles/PMC4564488/
- https://www.epa.gov/pesticides/nematicides
- https://www.gardeningknowhow.com/plant-problems/pests/nematodes/root-knot-nematodes.htm






